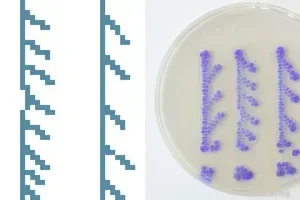
点击放大 图片
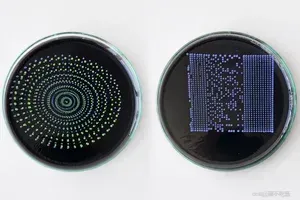
点击放大 图片

OpenLH:用于生物学创造性实验的开放式液体处理系统

OpenLH 基于开源机械臂 ( uArm Swift Pro ),支持创意探索。随着精密机械臂成本的下降,我们希望打造一款易于组装、由现有组件制成、精度达到黄金标准且价格仅为 1000 美元左右的液体处理机器人。此外,OpenLH 具有可扩展性,这意味着可以添加更多功能,例如用于图像分析和实时决策的摄像头,或将机械臂安装在线性执行器上以扩大工作范围。为了控制机械臂,我们制作了一个简单的块状界面和一个用于生物打印图像的图片打印界面块。
1
材料

2
主要部分

3
如何构建末端执行器

4
制作注射泵

5
设置

6
使用 Blockly 对 Arm 进行编程

7
用图片将微生物打印到打印块上

8
有效的液体处理

0
0
0猜你喜欢
评论/提问(已发布 0 条)
0

qq空间
微博
复制链接
分享